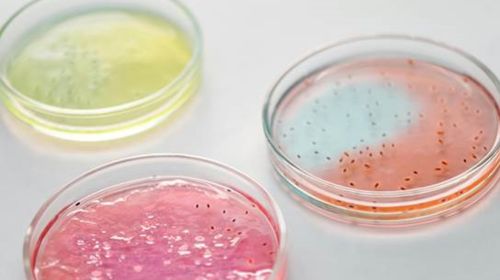

Las comunidades microbianas desempeñan funciones fundamentales tanto en entornos naturales como biotecnológicos. Para conocer cómo afecta la inclusión de un organismo a la comunidad no basta con saber si este desempeñará o no una función determinada, es necesario identificar de forma cuantitativa y precisa las interacciones óptimas entre los organismos y su entorno. Un trabajo liderado por el Instituto de Biología Funcional y Genómica (IBFG-CSIC-USAL), centro mixto del Consejo Superior de Investigaciones Científicas (CSIC) y la Universidad de Salamanca (USAL), ha demostrado que estas interacciones entre especies pueden estudiarse utilizando el mismo tipo de modelos estadísticos que han servido para entender y predecir interacciones entre genes. Los resultados, publicados en la revista Cell, abren la puerta a numerosas aplicaciones en biotecnología.
“Las múltiples funciones de las comunidades microbianas surgen de una compleja red de interacciones entre los organismos y su entorno. Esto dificulta nuestra capacidad para predecir y aprovechar el potencial de los microorganismos para aplicaciones biotecnológicas”, señala Juan Diaz-Colunga, primer autor del artículo e investigador del IBFG-CSIC-USAL. Por ello, el equipo de investigación formó cientos de ecosistemas microbianos artificiales con el fin de explicar la relación entre las especies que forman un ecosistema y sus propiedades.
En el trabajo se han empleado modelos predictivos que reflejan los patrones de “epistasis global” (circunstancia por la que la expresión de un gen se modifica debido a la expresión de otros genes) de los que se tiene constancia en genética. Estos modelos, trasladados a los ecosistemas, permiten la interpretación cuantitativa de la función ecológica en términos de interacciones por pares entre los miembros de la comunidad.
“Podríamos decir que el “juego” entre genes y el “juego” entre especies tiene las mismas reglas, al menos desde un punto de vista matemático. Si gracias a estos modelos somos capaces de hacer ingeniería genética, también deberíamos ser capaces de hacer ingeniería ecológica: diseñar comunidades completas que realicen eficientemente tareas importantes en biotecnología”, apunta Diaz-Colunga.
El hallazgo tiene implicaciones prácticas muy importantes, como destaca Álvaro Sánchez, también autor del estudio y científico del IBFG-CSIC-USAL: “Nuestros resultados abren una vía inexplorada para predecir cuantitativamente la función de los consorcios microbianos a partir de su composición. Esto allana el camino para predecir la función biológica a muchas escalas, desde genes y organismos hasta ecosistemas”.